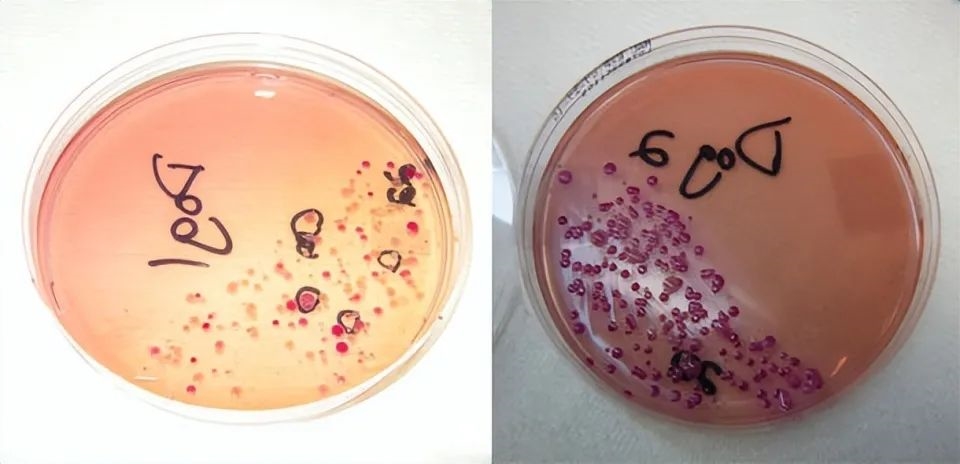

现代哺乳动物很少拥有毒液,因为恐龙灭绝后,哺乳动物迅速崛起,占据了最高的生态位,它们通常使用更高效的捕食方法——用牙齿和利爪来快速杀死猎物,而不是缓慢毒杀。只有一些非常古老的哺乳动物依然拥有分泌毒液的能力,总体来看目前已知的只有三种,一些鼩鼱,一些蝙蝠和鸭嘴兽等。
但是,这并不意味着大部分哺乳动物的咬伤就没有危险,被无毒哺乳动物咬伤也可能是致命的,这是因为口腔中的细菌。
然而,有一个有趣的说法,就是被人类咬伤比大部分动物咬伤都危险,甚至可能比科莫多巨蜥咬伤还危险。
还有数据支持,在咬伤接诊病例中,犬类咬伤并导致感染和引发传染病的患者只有10%-20%,而被人咬伤的感染和传染病风险高达 45%-55%。
另一方面,人口腔中至少生活着700种不同细菌,而科莫多巨蜥的口腔大约50种细菌左右,比人的要少得多。
为什么人类咬伤风险很高?
哺乳动物的身体环境就是微生物的温床,因为环境温度恒定,所以人类口腔的细菌种类比科莫多巨蜥多是很正常的。
但是,这并不意味着人类咬伤真的比科莫多巨蜥要危险,毕竟人家就是靠“咬伤”吃饭的,而我们的“咬伤”只是业余“爱好”而已,爱好最好别和别人吃饭的技能相提并论。
科莫多巨蜥的口腔中细菌种类虽然很少,但是它们致命细菌的比例极高,至少有10%以上的细菌注入温血动物血液会致命,而且它们还会分泌毒液,同样也相当致命。
人的口腔只是细菌种类多而已,真正致命的并不多,主要是感染风险极高。
很难说人类口腔中到底同时生活着多少细菌,但是一些学者给出的数据是200亿,每1毫升的唾液中可能都包含超过1亿个微生物。
不过,每种细菌的数量并不是绝对的,取决于口腔健康情况和吃的食物类型。
对于健康的个人而言,口腔庞大的微生物群落其实是很难引起疾病的,一方面是微生物很难有效对人造成伤害,即便进入胃部很难通过胃酸那一关。
另一方面是,健康的口腔其实是一个相对稳定的生态,各种微生物相互抗衡,很难有一种会突然爆发。
但是脱离口腔就不一样了,有研究发现脱离口腔的微生物增长速度是在口腔中的20倍,这个其实和一些动植物因为环境改变而引发泛滥成灾是一样的。
所以,当皮肤被咬破的时候,这些细菌进入组织引发感染很正常,而许多感染不及时治疗的话也非常危险,被人咬伤而截肢的新闻还是经常有报道的。
被咬伤和截肢相关的新闻截图
但是,为什么犬类的咬伤相对安全呢?
首先,人类的口腔与犬类口腔相比,细菌种类总量上确实人类会更多一点,但是并没有像科莫多巨蜥那样差了一个数量级。
犬类的口腔也至少包含了600多种细菌,与人类基本相当,只是种类和数量上都与人类相差甚远[1]。
犬类口腔中的革兰氏阴性菌比例远高于人类口腔,其原因是革兰氏阴性菌主要生活在肠道,而犬类喜欢嗅pp和肠道里出来的物质。
图:犬类口腔细菌培养
细菌种类对伤口引发感染的概率影响不是特别大,许多厌氧细菌都很容易引发感染,真正让犬类咬伤风险更低的原因是它们口腔的细菌数量较少,以及携带传染病病原体的可能性更低。
由于犬类通过呼吸散热,所以经常大口喘气,细菌可能在这个过程中被排出了,所以犬类的细菌量比人类小一个数量级。
另一方面就是传染病,人类的口腔中可能包含许多能够通过血液传播的病原体,特别是那些病毒,而犬类则很少,毕竟跨物种了,病毒很难执行感染。
那么,被人类咬伤可能会感染哪些疾病呢?
很多人可能都听说过“接吻病”,它是由EB病毒感染导致的,通常吸入感染者的唾沫的时候就会被感染。
其实唾液中有很多不需要通过咬伤就能传播的疾病,比如最早禁止吐痰的原因就是为了控制结核杆菌(肺结核)的传播。
但是,像结核杆菌这种唾沫就能传播的病原体,其实也可以通过血液传播,所以被咬伤的话,被感染的概率也很高。
另外还有一些只能通过血液传播的,它们在正常情况下很难传播,除非是口腔内有破损,但是咬伤情况下就很容易传播。
目前在人咬伤并感染传染病的案例中,最为普遍的就是乙肝和丙肝,全世界超过6%的人口患有乙肝和超过3%的人口患有丙肝,每10个人中差不多就有一个是这座肝炎患者,而两者的病毒都会出现在口腔中,并通过血液传播。
有意思的是,如果咬人的那位不是乙肝或丙肝患者,而被咬的人正好是的话,它也会传播给咬人的那位。
所以,我看到有医生建议,如果被人咬伤的话,最好两个人都去一下打疫苗。
另外,HIV和狂犬病都会通过人咬伤来传播,只是都非常罕见。
HIV被认为无法通过唾液传播,但是确实有因为被艾滋病患者咬伤而感染病毒的,而狂犬病是绝对可以通过咬伤传播。
最后
抛开人类有着可怕的唾液不谈,很多人认为人的牙齿不是很锋利,咬伤不会很严重,其实也不是这样的。
人的牙齿确实很难穿透皮肤,但是人的咬合力其实还是可以的,所以它可以在不破坏皮肤的情况下伤害内部皮下结构,导致一些骨骼和肌肉受损,严重的话也挺可怕的。
参考资料:
[1].https://www.amnh.org/learn-teach/curriculum-collections/young-naturalist-awards/winning-essays/2011/are-dogs-tongues-really-cleaner-than-humans